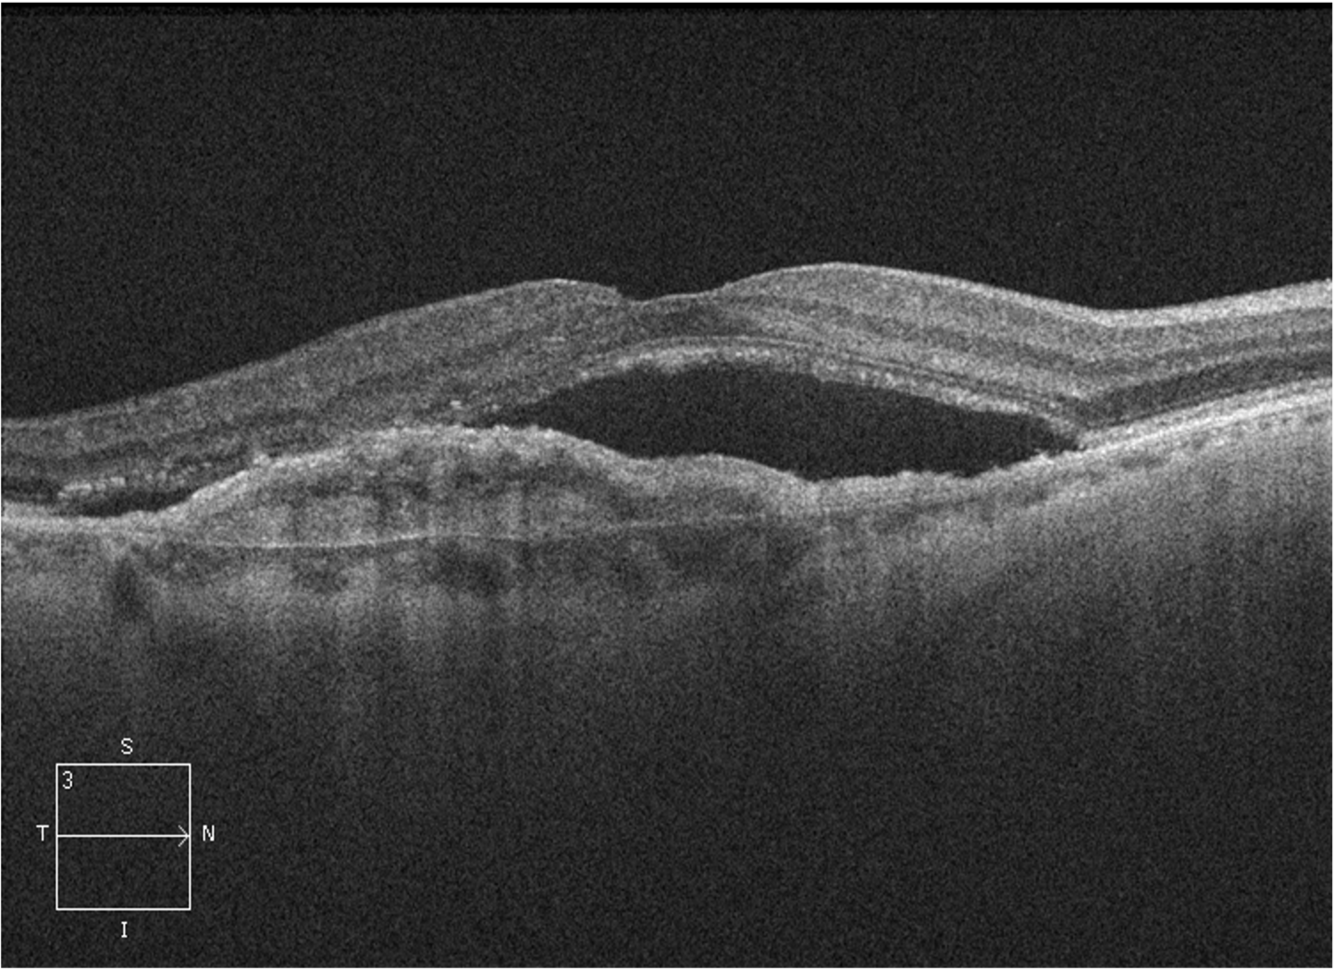

Drusen AMD

Drusen AMD

Focal Hyperpigmentation AMD

Focal Hyperpigmentation AMD

Geographic atrophy late AMD

Geographic Atrophy late AMD

Clinical Features of Late AMD: Geographic Atrophy

Clinical Features of Late AMD: Choroidal Neovascularisation

End stage of wet AMD, a disciform scar.
Neovascular AMD with haemorrhage.

Late WET AMD: Pigment Epithelial Detachment

Reticular Pseudodrusen AMD

Drusen AMD OCT

This image shows an OCT scan through a highly disordered macula. The large dark ‘bubbles’ in the inner retina show the presence of intraretinal fluid.
In this image, the dark area is beneath the retina, but inner to the RPE – this demonstrates subretinal fluid.
There is also an elevated region beneath the retinal pigment epithelium, which indicates the presence of a neovascular membrane.

Geographic atrophy AMD

Clinical Investigation of AMD: fundus autofluorescence

- Tiny little speckles in macula called hard drusens
- Cause lots of hard drusens, px is at risk of getting hard drusen AMD

- Lots of soft drusen in macula
- Intermediate AMD

– Lots of soft drusen in macula
- Focal pigmentary changes
- Intermediate AMD

- Neovascular membrane
- Haemorrhage

- End stage dry amd
- LARGE confluent drusens
- Geographic atrophy


